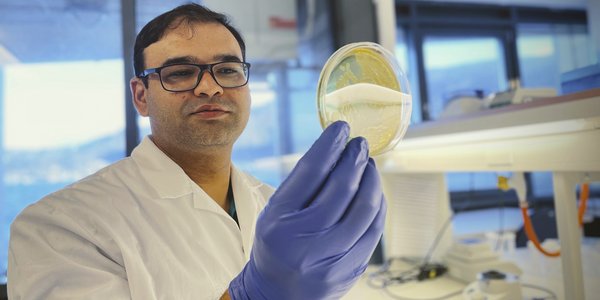
En forsker i hvit labfrakk og blå plasthansker er på labben. I hånden holder han en petriskål med prøver.

Nyheter
Resultat: (224) Viser 1 - 30

Dette er havets egen julepynt
18.12.2024

Sjå korallrevet minutt for minutt
11.12.2024

kronikk
Fiskeriforskning i utfordrende tider
10.12.2024

Ber FN ta kraftige plast-grep
26.11.2024
HI-historie
Havets overgangsalder
25.11.2024

kronikk
Kan blåskjell gjøre laksen norsk igjen?
22.11.2024
Krabbetokt utenfor kontorvinduet
19.11.2024

Rekeråd: Rår om auka kvote i Barentshavet
14.11.2024
Fra kråkebolleørken til frodig tareskog
13.11.2024

Utfordringer og muligheter med steril laks
11.11.2024

Leppefisk-råd: Same procedure as last year
06.11.2024

Skremmelyder kan redusere bifangst av måker
06.11.2024

Oppdatert kvoteråd for nordsjøtorsk
04.11.2024